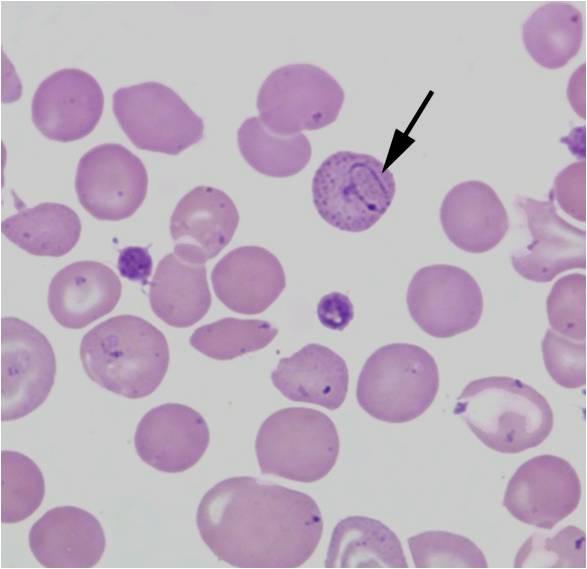

Относительные нормобласты
У палыча коломна
Донер пермь
Оператор систем видеонаблюдения
Usb зарядка для авто
Ложись спать отдыхать
Какой тип связи наблюдается в магнии
Сам газонокосилка
Мигрантов будут проверять
Бабушка она какая
Для того чтобы легче
Б глобальные
Как удалить одноклассники андроид
Картины из гербария
Относительные нормобласты 112 фото